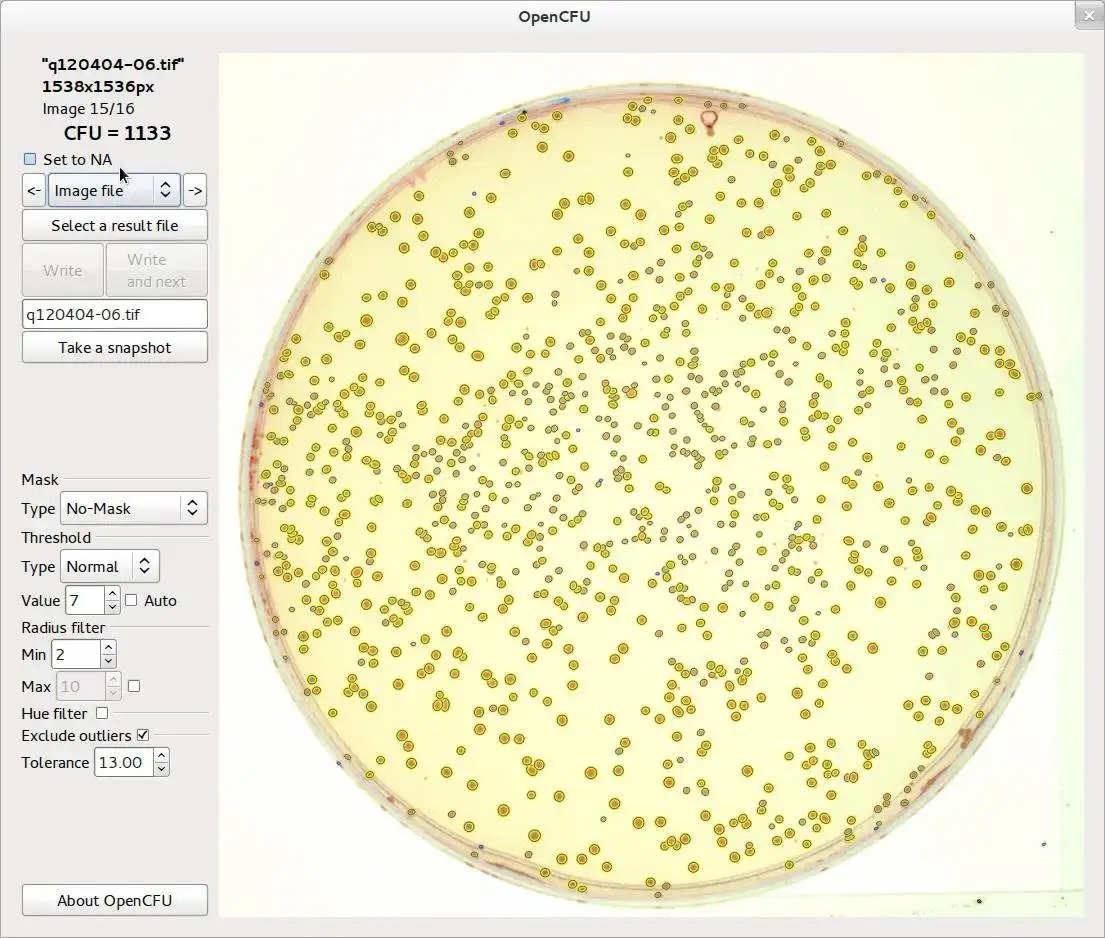

This is the Linux app named OpenCFU to run in Linux online whose latest release can be downloaded as OpenCFU-3.2.tar.gz. It can be run online in the free hosting provider OnWorks for workstations.
Download and run online this app named OpenCFU to run in Linux online with OnWorks for free.
Follow these instructions in order to run this app:
- 1. Downloaded this application in your PC.
- 2. Enter in our file manager https://www.onworks.net/myfiles.php?username=XXXXX with the username that you want.
- 3. Upload this application in such filemanager.
- 4. Start the OnWorks Linux online or Windows online emulator or MACOS online emulator from this website.
- 5. From the OnWorks Linux OS you have just started, goto our file manager https://www.onworks.net/myfiles.php?username=XXXXX with the username that you want.
- 6. Download the application, install it and run it.
SCREENSHOTS
Ad
OpenCFU to run in Linux online
DESCRIPTION
OpenCFU is a completely open source lightweight application designed to enumerate clustered circular objects such as bacterial colonies. It can handle digital pictures as well as live stream from a video device/webcam. OpenCFU is cross-platform, fast, reliable and allows the user to implement intuitive filters.Additional information is provided on the website: http://opencfu.sourceforge.net/
OpenCFU is published on PLoS ONE:
http://www.plosone.org/article/info%3Adoi%2F10.1371%2Fjournal.pone.0054072
Audience
Healthcare Industry, Science/Research
User interface
Command-line, GTK+
Programming Language
C++
This is an application that can also be fetched from https://sourceforge.net/projects/opencfu/. It has been hosted in OnWorks in order to be run online in an easiest way from one of our free Operative Systems.